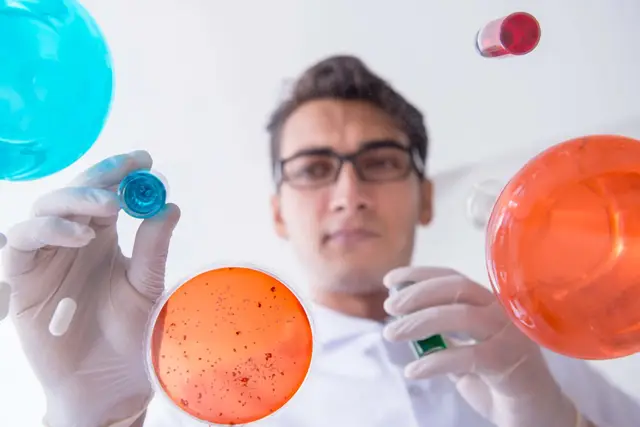
Student with gloves and beakers high school research

STUDENT SPOTLIGHTS
8 minute read
High School Cancer Research Student Ojas Writes a 30-page Paper
Jan 7, 2021
Based on our experience at some of the top research institutions, the Polygence team and community have a lot of insights to offer you on all sorts of topics!